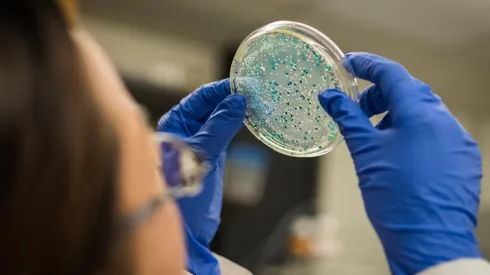
¿Las bacterias ayudando a la vacuna contra el Covid-19?

No es secreto que la población adulta mayor ha sido una de las más golpeadas por la pandemia. De hecho, son prioridad en el proceso de vacunación contra el Covid-19. ¿Pero cómo se puede comprobar la efectividad de la inoculación en este rango etáreo? Un par de científicos chilenos se propusieron investigar esta duda, y creen que las bacterias del intestino podrían tener la respuesta.
Erick Riquelme y Felipe Court, investigadores del Centro de Gerociencia, Metabolismo y Salud Mental (Gero), y del Centro de Biología Integrativa de la Universidad Mayor, desarrollan un estudio inédito que relaciona la microbiota de los adultos mayores en Chile con la eficacia de la vacuna contra la enfermedad provocada por el virus SARS-CoV-2.
¿Por qué las personas de edad avanzada son las más susceptibles al virus? Básicamente, según explica el Dr. Riquelme, se debe a que existe un proceso llamado “inmunosenescencia”, donde el sistema inmune y su capacidad de responder a patógenos como el coronavirus, se ve suprimido y disminuye su labor de defender el organismo ante agentes externos.
Por otro lado, Riquelme afirma que “se sabe bastante que la microbiota -o flora intestinal- tiene una interacción directa con el sistema inmune. Desde que nacemos hasta la vida adulta, ésta tiene una participación en el entrenamiento de las defensas”. Esta microbiota, que consiste en un conjunto de bacterias inofensivas para el organismo y que residen en el intestino, envían señales al sistema inmune para que se mantenga activo.

El investigador explica, además, que es importante entender cómo la flora bacteriana y el sistema inmune se comunican para mantener las defensas activas. Aquí es donde surge también la interrogante sobre la eficacia de las vacunas, y por qué suelen tener una distinta respuesta en personas jóvenes y en adultos mayores. “Hay un gran porcentaje de la población, y no se sabe con exactitud, que a pesar de estar vacunado no genera los suficientes anticuerpos”, explica. Una de las formas de entender este proceso será a través del estudio que los doctores Riquelme y Court realizan.
“Queremos entender si la microbiota tiene alguna relación con este grado de respuesta que se va a obtener con la vacunación contra el coronavirus. También lo podemos extrapolar a otras vacunaciones como la de la influenza”, añade. De esta manera, el estudio podrá determinar cómo la respuesta del sistema inmune puede estar relacionada con la microbiota y la respuesta de la vacunación.

Erick Riquelme, investigador del Centro de Gerociencia, Metabolismo y Salud Mental (Gero), y del Centro de Biología Integrativa de la Universidad Mayor.
Cómo entrenar el sistema inmune
Para realizar este estudio, los investigadores tomarán muestras de sangre y deposiciones de un grupo de personas de entre 70 y 90 años, que no tengan enfermedades autoinmunes y que hayan recibido la tercera dosis de vacunación contra el Covid-19. De las muestras sanguíneas se podrán contabilizar y analizar los anticuerpos generados con la vacuna, y también citoquinas, que son moléculas generadas por el sistema inmune en el mismo suero de la sangre. Mientras que, a través del estudio de las deposiciones será posible entender qué bacterias existen en el organismo de cada persona, y saber cuál es su distribución en cuanto a número y porcentaje en la muestra.

Felipe Court, investigador de Gero explicando las fases de este nuevo estudio.
“Si los resultados son satisfactorios, la segunda fase buscará planificar estrategias para modificar la microbiota a través de cambios en la dieta, probióticos, restricción calórica y otras, de modo de activar el sistema inmune en adultos mayores e incrementar la efectividad de la vacunación”, explica Felipe Court. Ante esta premisa, según los investigadores es posible “entrenar” a la flora bacteriana para que puedan fortalecer el sistema inmune, especialmente de los adultos mayores.
El consumo de alimentos ricos en fibras y vegetales ayuda a aumentar la calidad de estas bacterias que ayudan a mejorar el sistema inmune. En cambio, el consumo indiscriminado de antibióticos genera un desmedro en esta flora bacteriana. “Si somos un poco más exitosos, podemos incluso diseñar algún tipo de consorcio microbiano, o probiótico, que le podamos dar a las personas y que antes de la vacunación fortalezcan su sistema inmune y mejoren su respuesta a la inoculación”, detalla Riquelme.
Esta investigación es una de las seis propuestas seleccionadas por el Concurso Desafío Global en Longevidad Saludable, de la Agencia Nacional de Investigación y Desarrollo (ANID) y la Academia Nacional de Medicina de Estados Unidos. Durante los próximos meses, tanto Riquelme como Court desarrollarán este estudio donde recolectarán, analizarán y buscarán soluciones para mejorar la eficacia de las vacunas a través de las bacterias que habitan nuestro cuerpo.